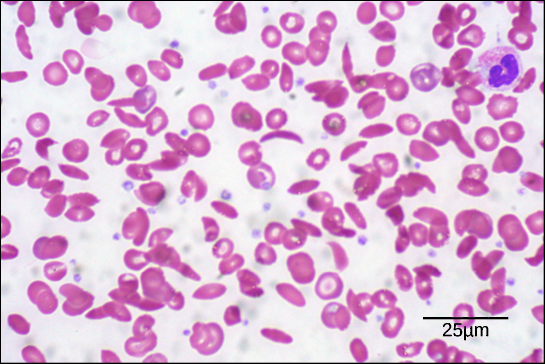

§12. ՍՊԻՏԱԿՈՒՑՆԵՐԻ ԳՈՐԾԱՌՈՒՅԹՆԵՐԸ
Սպիտակուցի կառուցվածքային հաջորդականությունը
Սպիտակուցի կառուցվածքի ամենապարզ մակարդակը՝ առաջնային կառուցվածքը, պոլիպեպտիդային շղթայում ամինաթթուների հաջորդականությունն է։ Օրինակ՝ ինսուլին հորմոնը պոլիպեպտիդային երկու շղթա ունի՝ A և B, որոնք պատկերված են ստորև։ (Այստեղ պատկերված է կովի ինսուլինը, թեև վերջինիս կառուցվածքը նման է մարդու ինսուլինին): Շղթաներից յուրաքանչյուրն ունի իր ամինաթթվային հաջորդականությունը, որոնք միացած են որոշակի հաջորդականությամբ։ Օրինակ՝ A շղթան N-ծայրում սկսվում է գլիցինով, C-ծայրում ավարտվում է ասպարագինով և տարբերվում է B շղթայի հաջորդականությունից։
Ի՞նչ է տեղի ունենում S-S կապերի հետ։
Հավանաբար նկատեցիր, որ ինսուլինի շղթաները միացած են ցիստեինների միջև ծծումբ պարունակող կապերով։ Պետք չէ շփոթվել․ թեև այս կապերը ինսուլինի ընդհանուր կառուցվածքի համար շատ կարևոր են, դրանք վերջինիս առաջնային կառուցվածքի մաս չեն։ Երկսուլֆիդային կապերի մասին ավելին կխոսենք այլ բաժիններում։
Սպիտակուցի հաջորդականությունը որոշվում է այդ սպիտակուցը (կամ մի քանի ենթամիավորներից կազմված սպիտակուցի մի մասը) կոդավորող գենի ԴՆԹ-ով: Գենում ԴՆԹ-ի հաջորդականության փոփոխությունը կարող է հանգեցնել սպիտակուցի ամինաթթվային հաջորդականության փոփոխության։ Սպիտակուցի հաջորդականության մեջ անգամ մեկ ամինաթթվի փոփոխությունը կարող է ազդել սպիտակուցի ընդհանուր կառուցվածքի և գործառույթի վրա։
Օրինակ՝ մեկ ամինաթթվի փոփոխությունը կապված է մանգաղաբջջային սակավարյունության հետ, որը ժառանգական հիվանդություն է և վնասում է արյան կարմիր բջիջները։ Մանգաղաբջջային սակավարյունության դեպքում հեմոգլոբինը (այն սպիտակուցը, որն արյան մեջ փոխադրում է թթվածին) կազմող պոլիպեպտիդային չորս շղթաներից մեկում հաջորդականությունը մի քիչ փոփոխված է։ Գլուտամինաթթուն, որը սովորաբար հեմոգլոբինի β շղթայի (հեմոգլոբինը կազմող սպիտակուցի երկու տեսակի շղթաներից մեկը) վեցերորդ ամինաթթուն է, փոխարինված է վալինով։ Այդ փոխարինումը ներկայացված է β շղթայի մի հատվածի համար ստորև ներկայացված գծապատկերում:
Ամենաուշագրավը հաշվի առնելն է, որ հեմոգլոբինի մոլեկուլը բաղկացած է երկու α և երկու β շղթաներից, որոնցից յուրաքանչյուրը բաղկացած է մոտ 150 ամինաթթվից՝ ընդհանուր առմամբ մոտ 600 ամինաթթու ամբողջ սպիտակուցում: Նորմալ հեմոգլոբինի մոլեկուլի և մանգաղաձև բջջի մոլեկուլի միջև տարբերությունն ընդամենը 2 ամինաթթու է մոտավորապես 600-ից:
Այն մարդը, որի մարմնում միայն այսպիսի փոփոխված հեմոգլոբին է առաջանում, տառապում է մանգաղաբջջային սակավարյունության ախտանշաններով: Սա տեղի է ունենում, քանի որ գլուտամինաթթու-վալին ամինաթթվային փոխարինման արդյունքում հեմոգլոբինի մոլեկուլները կուտակվում են երկար մանրաթելերի տեսքով։ Այս մանրաթելերը սկավառակաձև արյան կարմիր բջիջները վեր են ածում կիսալուսնաձևի։ Ստորև ներկայացված արյան նմուշում կարելի է տեսնել նորմալ, սկավառակաձև բջիջների հետ խառնված «մանգաղաձև» բջիջների օրինակներ։
Մանգաղաձև բջիջները արյունատար անոթներով անցնելիս կուտակումներ են առաջացնում և խաթարելով արյան բնականոն հոսքը՝ կարող են մանգաղաբջջային սակավարյունություն ունեցող մարդու առողջության համար լուրջ խնդիրներ առաջացնել՝ ներառյալ շնչարգելություն, գլխապտույտ, գլխացավ և որովայնի ցավ։
Սպիտակուցի կառուցվածքի հաջորդ մակարդակը երկրորդային կառուցվածքն է, երբ պոլիպեպտիդը մոլեկուլի կմախքը կազմող ատոմների միջև փոխազդեցությունների շնորհիվ որոշ հատվածներում ոլորվում է։ (Կմախքը վերաբերում է պոլիպեպտիդային շղթային՝ բացի R խմբերից։ Այսինքն՝ այստեղ նկատի ունենք, որ երկրորդային կառուցվածքը R խմբերը չի ներառում): Երկրորդային կառուցվածքի ամենատարածված տեսակներն են α պարույրը և β ծալքավոր կառուցվածքը։ Այս երկու կառուցվածքն էլ պահպանվում են մի ամինաթթվի կարբոնիլի O-ի և մյուսի ամինաթթվի H-ի միջև առաջացած ջրածնական կապերի շնորհիվ։
α պարույրի մի ամինաթթվի կարբոնիլ խումբը (C=O) ջրածնային կապով կապված է չորս ամինաթթու հետո գտնվող ամինաթթվի ամինախմբի H-ին (N-H) (օրինակ՝ 1-ին ամինաթթվի կարբոնիլ խումբը ջրածնային կապ կառաջացնի 5-րդ ամինաթթվի N-H-ի հետ): Այս կերպ կապի առաջացումը պոլիպեպտիդային շղթան վերածում է ոլորված ժապավենի նմանվող պարուրաձև կառուցվածքի, որի յուրաքանչյուր պարույրը պարունակում է 3,6 ամիինաթթու։ Ամինաթթուների R խմբերը α պարույրից դուրս են, որտեղ էլ կարող են փոխազդեցության մեջ մտնել³։
β ծալքավոր կառուցվածքում պոլիպեպտիդի երկու կամ ավելի հատվածներ իրար կողք են շարվում՝ առաջացնելով ծալքավոր կառուցվածք, որը պահվում է ջրածնային կապերով։ Ջրածնային կապերն առաջանում են կարբոնիլ խմբի և ամինախմբի միջև, իսկ R խմբերը ծալքի հարթությունից վերև ու ներքև են ուղղվում³։ β ծալքավոր կառուցվածքի շղթաները կարող են իրար զուգահեռ լինել՝ ունենալ միևնույն ուղղությունը (այսինքն՝ դրանց N- և C-ծայրերը կհամապատասխանեն) կամ հակազուգահեռ՝ ունենալ հակառակ ուղղություններ (այսինքն՝ շղթաներից մեկի N-ծայրը կգտնվի մյուս շղթայի C-ծայրի դիմաց)։
Որոշ ամինաթթուներ հայտնաբերվել են միայն α պարույրի կամ β ծալքավոր կառուցվածքի ձևով։ Օրինակ՝ պրոլին ամինաթթուն երբեմն կոչվում է «պարույր քանդող», քանի որ իր անսովոր R խումբը (որն օղակ առաջացնելու համար միանում է ամինախմբին) շղթայում թեքում է առաջացնում, որն անհամատեղելի է պարույրի հետ4։ Պրոլինը սովորաբար լինում է երկրորդային կառուցվածքներում եղած թեքություններում։ Նույն կերպ, տրիպտոֆան, թիրոզին և ֆենիլալանին ամինաթթուները, որոնք իրենց R խմբերում մեծ օղակաձև կառուցվածք են պարունակում, հաճախ հայտնաբերվում են β ծալքավոր կառուցվածքով, հավանաբար այն պատճառով, որ այդպիսի կառուցվածքը կողմնային շղթայի համար մեծ տարածություն է ապահովում4։
Բազմաթիվ սպիտակուցներ պարունակում են և՛ α պարույր, և՛ β ծալքավոր կառուցվածք, իսկ որոշները՝ այս երկուսից միայն մեկը (կամ երկուսից ոչ մեկն էլ չեն պարունակում)։
Պոլիպեպտիդի ամբողջական եռաչափ կառուցվածքը կոչվում է երրորդային կառուցվածք։ Երրորդային կառուցվածքն առաջանում է գլխավորապես սպիտակուցը կազմող ամինաթթուների R խմբերի միջև փոխազդեցությունների արդյունքում։
R խմբերի փոխազդեցությունները, որոնք նպաստում են երրորդային կառուցվածքին, ներառում են ջրածնային, իոնային կապերը, դիպոլ-դիպոլ փոխազդեցությունները, Լոնդոնյան դիսպերսիոն ուժերը, այնսինքն՝ ոչ կովալենտային կապերի ամբողջ ծավալը։ Օրինակ՝ միանման լիցք ունեցող R խմբերը վանում են միմյանց, իսկ հակառակ լիցք ունեցողները կարող են իոնային կապեր առաջացնել։ Նույն կերպ՝ բևեռային R խմբերը կարող են ջրածնային կապեր և այլ դիպոլ-դիպոլ փոխազդեցություններ առաջացնել։ Երրորդային կառուցվածքի համար նաև կարևոր են հիդրոֆոբ փոխազդեցությունները, երբ ոչ բևեռային, հիդրոֆոբ R խմբեր ունեցող ամինաթթուները խմբավորվում են սպիտակուցի ներսում՝ հիդրոֆիլ ամինաթթուներին թողնելով դրսում՝ փոխազդելու միջավայրում եղած ջրի մոլեկուլների հետ։
Եվ վերջապես՝ կովալենտային կապի մի հատուկ տեսակ կա, որը նպաստում է երրորդային կառուցվածքին։ Դա երկսուլֆիդային կապն է։ Երկսուլֆիդային կապերը ցիստեինի՝ ծծումբ պարունակող կողմնային շղթաների միջև կովալենտային կապեր են, որոնք երրորդային կառուցվածքում եղած մյուս բոլոր կապերից ավելի ամուր են։ Դրանք գործում են որպես «անվտանգության քորոցներ»՝ պահելով պոլիպեպտիդի հատվածները միմյանց ամուր միացած։
Շատ սպիտակուցներ կազմված են պոլիպեպտիդային մեկ շղթայից և միայն առաջին երեք մակարդակներն ունեն (որոնք մինչև այժմ քննարկել ենք)։ Բայց որոշ սպիտակուցներ կազմված են պոլիպեպտիդային բազմաթիվ շղթաներից, որոնք կոչվում են ենթամիավորներ։ Երբ այս ենթամիավորները միանում են, առաջանում է սպիտակուցի չորրորդային կառուցվածքը։
Մենք արդեն խոսել ենք չորրորդային կառուցվածք ունեցող մի սպիտակուցի՝ հեմոգլոբինի մասին։ Ինչպես արդեն նշվել է, հեմոգլոբինը արյան մեջ թթվածին է տեղափոխում և կազմված է չորս ենթամիավորից՝ երկու α և երկու β շղթաներից։ Մեկ այլ օրինակ է ԴՆԹ պոլիմերազը։ Այն ֆերմենտ է, որը սինթեզում է ԴՆԹ-ի նոր շղթան և կազմված է տասը ենթամիավորից5º։
Ընդհանուր առմամբ, չորրորդային կառուցվածքը պահելու համար ենթամիավորները միանում են նույն տեսակի կապերով, որոնք նպաստում են երրորդային կառուցվածքին (ամենաթույլ կապերը, օրինակ՝ ջրածնային կապերը և Լոնդոնյան դիսպերսիոն ուժերը)։
Նյութի աղբյուրը՝ «Քան» ակադեմիա